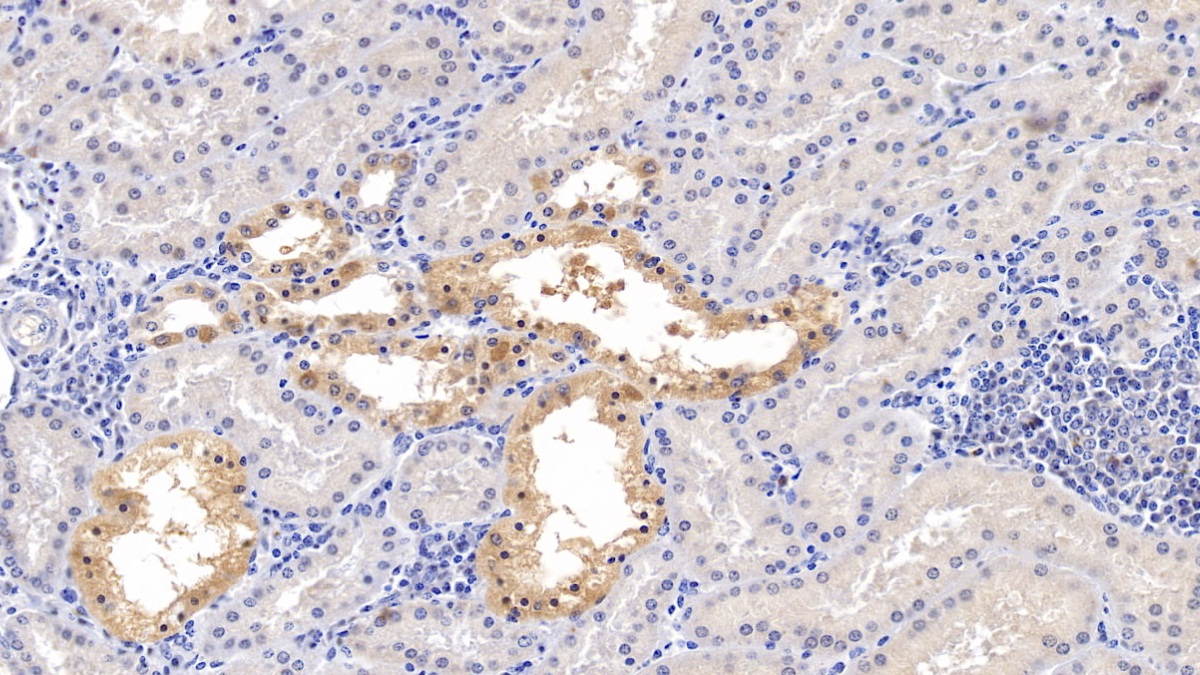

Polyclonal Antibody to Matrix Metalloproteinase 2 (MMP2)
CLG4; CLG4A; MMP-II; MONA; TBE-1; PEX; Gelatinase A; 72kDa Gelatinase; 72kDa Type IV Collagenase
- Product No.PAA100Hu02
- Organism SpeciesHomo sapiens (Human) Same name, Different species.
- SourcePolyclonal antibody preparation
- HostRabbit
- Potencyn/a
- Ig Type IgG
- PurificationAntigen-specific affinity chromatography followed by Protein A affinity chromatography
- LabelNone
- Immunogen RPA100Hu02-Recombinant Matrix Metalloproteinase 2 (MMP2)
- Buffer FormulationPBS, pH7.4, containing 0.02% NaN3, 50% glycerol.
- TraitsLiquid
- Concentration0.31mg/mL
- Organism Species Moren/a
- ApplicationsWB; IHC; ICC/IF
If the antibody is used in flow cytometry, please check FCM antibodies. - DownloadInstruction Manual
- UOM 20µl100µl 200µl 1ml 10ml
- FOB
US$ 63
US$ 147
US$ 210
US$ 525
US$ 2100
For more details, please contact local distributors!
SPECIFITY
The antibody is a rabbit polyclonal antibody raised against MMP2. It has been selected for its ability to recognize MMP2 in immunohistochemical staining and western blotting.
USAGE
Western blotting: 0.01-2µg/mL;
Immunohistochemistry: 5-20µg/mL;
Immunofluorescence: 5-20µg/mL;
Optimal working dilutions must be determined by end user.
STORAGE
Store at 4°C for frequent use. Stored at -20°C in a manual defrost freezer for two year without detectable loss of activity. Avoid repeated freeze-thaw cycles.
STABILITY
The thermal stability is described by the loss rate. The loss rate was determined by accelerated thermal degradation test, that is, incubate the protein at 37°C for 48h, and no obvious degradation and precipitation were observed. The loss rate is less than 5% within the expiration date under appropriate storage condition.
GIVEAWAYS
INCREMENT SERVICES
-
 Antibody Labeling Customized Service
Antibody Labeling Customized Service
-
 Protein A/G Purification Column
Protein A/G Purification Column
-
 Staining Solution for Cells and Tissue
Staining Solution for Cells and Tissue
-
 Positive Control for Antibody
Positive Control for Antibody
-
 Tissue/Sections Customized Service
Tissue/Sections Customized Service
-
 Phosphorylated Antibody Customized Service
Phosphorylated Antibody Customized Service
-
 Western Blot (WB) Experiment Service
Western Blot (WB) Experiment Service
-
 Immunohistochemistry (IHC) Experiment Service
Immunohistochemistry (IHC) Experiment Service
-
 Immunocytochemistry (ICC) Experiment Service
Immunocytochemistry (ICC) Experiment Service
-
 Flow Cytometry (FCM) Experiment Service
Flow Cytometry (FCM) Experiment Service
-
 Immunoprecipitation (IP) Experiment Service
Immunoprecipitation (IP) Experiment Service
-
 Immunofluorescence (IF) Experiment Service
Immunofluorescence (IF) Experiment Service
-
 Buffer
Buffer
-
 DAB Chromogen Kit
DAB Chromogen Kit
-
 SABC Kit
SABC Kit
-
 Long-arm Biotin Labeling Kit
Long-arm Biotin Labeling Kit
-
 Real Time PCR Experimental Service
Real Time PCR Experimental Service
| Magazine | Citations |
| Moleculer Vision | Bone morphogenetic protein-2: a potential regulator in scleral remodeling PubMed: PMC2605409 |
| Neuroimmunomodulation | Upregulated Expression of Matrix Metalloproteinases and Tissue Inhibitors of Matrix Metalloproteinases in BALB/c Mouse Brain Challenged with Japanese Encephalitis Virus Pubmed: source |
| Zahedan Journal of Research in Medical Sciences | The Effect of Acute Sub-Maximal Endurance Exercise on Serum Angiogenic Indices in Sedentary Men Zjrms: Source |
| Experimental Biology and Medicine | Acidic pH conditions mimicking degenerative intervertebral discs impair the survival and biological behavior of human adipose-derived mesenchymal stem cells Rsmjournals: Source |
| Experimental & Translational Stroke Medicine | Early outcome and blood-brain barrier integrity after co-administered thrombolysis and hyperbaric oxygenation in experimental stroke PubMed: 21679435 |
| PLoS One | Downregulation of CD9 in Keratinocyte Contributes to Cell Migration via Upregulation of Matrix Metalloproteinase-9 PubMed: PMC3797697 |
| PLoS ONE | A Combinatorial Relative Mass Value Evaluation of Endogenous Bioactive Proteins in Three-Dimensional Cultured Nucleus Pulposus Cells of Herniated Intervertebral Discs: Identification of Potential Target Proteins for Gene Therapeutic Approaches Plosone: Source |
| Clinical and Investigative Medicine | The protective effect of dexmedetomidine on bupivacaine-induced sciatic nerve inflammation is mediated by mast cells Pubmed: 23544611 |
| Physiol. Res. | The unwounded skin remodeling in animal models of diabetes types 1 and 2. Pubmed: 24020818 |
| Acta Histochemica | RNA interference-mediated knockdown of Notch-1 inhibits migration and invasion, down-regulates matrix metalloproteinases and suppresses NF-κB signaling pathway in trophoblast cells Pubmed: 24681113 |
| Peritoneal Dialysis | Can effluent matrix metalloproteinase 2 and plasminogen activator inhibitor 1 be used as biomarkers of peritoneal membrane alterations in peritoneal dialysis patients? Pubmed: 23994841 |
| Polski Przeglad Chirurgiczny | Concentration of gelatinases and their tissue inhibitors in pancreatic inflammatory and neoplastic tumors and their influence on the early postoperative course Pubmed: 23585206 |
| Thromb Haemost. | Analysis of the expression of nine secreted matrix metalloproteinases and their endogenous inhibitors in the brain of mice subjected to ischaemic stroke Pubmed:24671655 |
| Int Immunopharmacol.? | Cadherin-11 involves in synovitis and increases the migratory and invasive capacity of fibroblast-like synoviocytes of osteoarthritis Pubmed:25824718 |
| Journal of Perinatology | Increased expression of prostasin contributes to early-onset severe preeclampsia through inhibiting trophoblast invasion Pubmed:25078863 |
| Biomedical Materials | In vivo bioengineered ovarian tumors based on collagen, matrigel, alginate and agarose hydrogels: a comparative study Pubmed:25634132 |
| Stem Cells International | Matrix Metalloproteinase 9 Secreted by Hypoxia Cardiac Fibroblasts Triggers Cardiac Stem Cell Migration In Vitro Pubmed:25767513 |
| Physiology and Pharmacology | A Study on the Serum Levels of Angiogenic Factors in Response to Acute Long-term Submaximal Exercise in Sedentary Men Phypha:Source |
| Mediators of Inflammation | Metalloproteinases and Their Tissue Inhibitors in Comparison between Different Chronic Pneumopathies in the Horse Journals: Mi |
| Journal of Biomaterials and Tissue Engineering | MicroRNA-506 Up-Regulation Inhibits Growth and Invasion in Non-Small Cell Lung Cancer Cells by Possibly Targeting Sphingosine Kinase 1 Content: Asp |
| Biomedical Materials | In vivo PubMed: 25634132 |
| Int J Clin Exp Pathol | Up-regulation of microRNA-302a inhibited the proliferation and invasion of colorectal cancer cells by regulation of the MAPK and PI3K/Akt signaling pathways PubMed: 26191138 |
| Hattori and Ishihara Stem Cell Research & Therapy | Altered protein secretions during interactions between adipose tissue-or bone marrow-derived stromal cells and inflammatory cells PubMed: 25884474 |
| Biosens Bioelectron | Ultrasensitive photoelectrochemical immunoassay for CA19-9 detection based on CdSe@ZnS quantum dots sensitized TiO2NWs/Au hybrid structure amplified by quenching effect of Ab2@V3+ PubMed: 26433066 |
| Veterinary Parasitology | Expression of adhesion molecules, chemokines and matrix metallo- proteinases (MMPs) in viable and degenerating stage of Taenia solium metacestode in swine neurocysticercosis PubMed: 26412140 |
| Canadian Journal of Physiology and Pharmacology | Resveratrol reduces matrix metalloproteinases and alleviates intrahepatic cholestasis of pregnancy in rats Doi: Abs |
| PLASTIC AND AESTHETIC RESEARCH | A comparative study to evaluate the effect of limited access dressing on diabetic ulcers Article: 2347-9264 |
| Int J Mol Sci | Evodiamine Attenuates PDGF-BB-Induced Migration of Rat Vascular Smooth Muscle Cells through Activating PPARγ PubMed: 26703570 |
| Basic Research | CTGF upreCavia (Guinea pig )lation correlates with MMP-9 level in airway remodeling in a murine model of asthma Journal:27699 |
| International Journal of Oncology | 1, 25-Dihydroxyvitamin D3 alleviates salivary adenoid cystic carcinoma progression by suppressing GPX1 expression through the NF-κB pathway Pubmed:26782341 |
| International Journal of Pharmacology | Research Article Effects of DNMT and HDAC Inhibitors (RG108 and Trichostatin A) on NGF-induced Neurite Outgrowth and Cellular Migration profile:57162df608aebf0697f1843d |
| Journal of Stroke and Cerebrovascular Diseases | Epigallocatechin Gallate Extends the Therapeutic Window of Recombinant Tissue Plasminogen Activator Treatment in Ischemic Rats Pubmed:26851971 |
| VirusDisease | Circulating levels of matrix metalloproteinases and tissue inhibitors of matrix metalloproteinases during Japanese encephalitis virus infection Pubmed:26925446 |
| Cell Physiol Biochem. | MicroRNA-340 Induces Apoptosis and Inhibits Metastasis of Ovarian Cancer Cells by Inactivation of NF-x03BA;B1 Pubmed:27160777 |
| Int Wound J. | From varices to venous ulceration: the story of chronic venous disease described by metalloproteinases. Pubmed:26991748 |
| Biosensors and Bioelectronics | Ultrasensitive photoelectrochemical immunoassay for CA19-9 detection based on CdSe@ZnS quantum dots sensitized TiO2NWs/Au hybrid structure amplified by quenching effect of Ab2@V2+ conjugates science:S0956566315304474 |
| world journal of surgery | Metalloproteinases and Their Inhibitors in Patients with Inguinal Hernia. pubmed:28050662 |
| disease markers | Serum HMGB1 as a Potential Biomarker for Patients with Asbestos-Related Diseases. pubmed:28348451 |
| Balkan Medical Journal | Anti-inflammatory and Anti-apoptotic Effect of Valproic Acid and Doxycycline Independent from MMP Inhibition in Early Radiation Damage pubmed:27761275 |
| Microvascular Research | Pleiotropic effects of survivin in vascular endothelial cells. pubmed:27373518 |
| BMC Veterinary Research | Metalloproteinases and their inhibitors are influenced by inhalative glucocorticoid therapy incombination with environmental dust reduction in equine recurrent airway obstruction. pubmed:27938355 |
| Cellular Physiology and Biochemistry | MicroRNA-340 Induces Apoptosis and Inhibits Metastasis of Ovarian Cancer Cells by Inactivation of NF-x03BA;B1. pubmed:27160777 |
| Journal of Biomaterials and Tissue Engineering | MicroRNA-340 Targets NF-κB1 to Inhibit Cell Proliferation, Migration and Invasion in Hepatocellular Carcinoma Cell Line publication:306067745 |
| World Journal of Plastic Surgery | Superficial Burn Wound Healing with Intermittent Negative Pressure Wound Therapy UnderLimited Access and Conventional Dressings. pubmed:27853690 |
| Journal of Biomaterials and Tissue Engineering | Zoledronic Acid Inhibits TGF-β1-Induced the Proliferation, Migration and EMT Through Smad Pathway in Human Gingival Fibroblasts art00008 |
| Human cell | Liver X receptor α (LXRα) promoted invasion and EMT of gastric cancer cells by regulation of NF-κB activity pubmed:28091828 |
| Human Cell | MicroRNA-124 upregulation inhibits proliferation and invasion of osteosarcoma cells by targeting sphingosine kinase 1 pubmed:27743351 |
| Experimental Parasitology | Adhesion molecules, chemokines and matrix metallo-proteinases response after albendazole and albendazole plus steroid therapy in swine neurocysticercosis pubmed:28821422 |
| Human Cell | MicroRNA-30a functions as tumor suppressor and inhibits the proliferation and invasion of prostate cancer cells by down-regulation of SIX1 pubmed:28573504 |
| Cellular Physiology and Biochemistry | The MiR-495/Annexin A3/P53 Axis Inhibits the Invasion and EMT of Colorectal Cancer Cells pubmed:29224019 |
| International Wound Journal | From varices to venous ulceration: the story of chronic venous disease described by metalloproteinases pubmed:26991748 |
| Fundamental & Clinical Pharmacology | Epigallocatechin-3-gallate ameliorates intrahepatic cholestasis of pregnancy by inhibiting matrix metalloproteinase-2 and matrix metalloproteinase-9 DOI:10.1111/fcp.12294 |
| PLoS One | Pro-fibrotic compounds induce stellate cell activation, ECM-remodelling and Nrf2 activation in a human 3D-multicellular model of liver fibrosis pubmed:28665955 |
| Nanotoxicology | Cellular proliferation and differentiation induced by single-layer molybdenum disulfide and mediation mechanisms of proteins via the Akt-mTOR-p70S6K signaling pathway 10.1080/17435390.2017.1357213 |
| Archives of Medical Science | CTGF upregulation correlates with MMP-9 level in airway remodeling in a murine model of asthma. pubmed:28507585 |
| Molecular Medicine Reports | Lysyl oxidase is involved in synovial hyperplasia and angiogenesis in rats with collagen‑induced arthritis pubmed:28901438 |
| European Journal of Medicinal Chemistry | Syntenin-targeted peptide blocker inhibits progression of cancer cells Pubmed:29857221 |
| Journal of Neurochemistry | Liraglutide ameliorated peripheral neuropathy in diabetic rats: Involvement of oxidative stress, inflammation and extracellular matrix remodeling Pubmed:29572844 |
| Journal of Cellular Biochemistry | Matrix metalloproteinases‐2 (MMP‐2) and matrix metalloproteinases‐9 (MMP‐9) are differentially expressed in different regions of normal and preeclampsia … 10.1002:jcb.26849 |
| Inflammation | Extracellular Matrix Remodeling and Modulation of Inflammation and Oxidative Stress by Sulforaphane in Experimental Diabetic Peripheral Neuropathy Pubmed:29704151 |
| OncoTargets and Therapy | sirT4 acts as a tumor suppressor in gastric cancer by inhibiting cell proliferation, migration, and invasion Pubmed:30022839 |
| Biomed Research International | CD30 Is Highly Expressed in Chronic Obstructive Pulmonary Disease and Induces the Pulmonary Vascular Remodeling Pubmed:29984229 |
| APMIS | Hepatoprotectivity of Panduratin A against liver damage: demonstration with a rat model of cirrhosis induced by thioacetamide Pubmed:30058214 |
| Molecular Medicine Reports | Effect of a synthetic inhibitor of urokinase plasminogen activator on the migration and invasion of human cervical cancer cells in vitro Pubmed:29328476 |
| Oncology Letters | miRNA‑199a‑5p suppresses proliferation and invasion by directly targeting NF‑κB1 in human ovarian cancer cells 10.3892:ol.2018.9170 |
| Taiwanese Journal of Obstetrics & Gynecology | HMGB1-RAGE signaling pathway in pPROM Pubmed:29673663 |
| Open Medicine | MMP-2 and TIMP-2 in patients with heart failure and chronic kidney disease Pubmed:29915813 |
| Pediatric Research | Anti-thymic stromal lymphopoietin antibody suppresses airway remodeling in asthma through reduction of MMP and CTGF. Pubmed: 30464333 |
| Advanced Healthcare Materials | Impact of Hydrogel Elasticity and Adherence on Osteosarcoma Cells and Osteoblasts Pubmed: 30838809 |
| Cellular & Molecular Biology Letters | MiR-613 inhibits proliferation and invasion and induces apoptosis of rheumatoid arthritis synovial fibroblasts by direct down-regulation of DKK1 |
| Mediators of Inflammation | Metalloproteinases and their Inhibitors under the Course of Immunostimulation by CPG-ODN and Specific Antigen Inhalation in Equine Asthma |
| Journal of endovascular therapy: an official journal of the International Society of Endovascular Specialists | Correlation of Baseline Plasma and Inguinal Connective Tissue Metalloproteinases and Their Inhibitors With Late High-Pressure Endoleak After Endovascular … Pubmed: 31464166 |
| Oncology Research | MicroRNA-6884-5p regulates the proliferation, invasion and EMT of gastric cancer cells by directly targeting S100A16 Pubmed: 31796150 |
| Scientific Reports | Matrix metallopeptidase expression and modulation by transforming growth factor-β1 in equine endometrosis Pubmed: 31980722 |
| Acta Biomaterialia | Stiffness of the Aligned Fibers Affects Structural and Functional Integrity of the Oriented Endothelial Cells Pubmed: 32205213 |
| JOURNAL OF THROMBOSIS AND THROMBOLYSIS | Extracellular matrix collagen biomarkers levels in patients with chronic thromboembolic pulmonary hypertension Pubmed: 33175289 |
| JOURNAL OF ETHNOPHARMACOLOGY | Danlou tablet inhibits the inflammatory reaction of high-fat diet-induced atherosclerosis in ApoE knockout mice with myocardial ischemia via the NF-κB signaling … Pubmed: 32745509 |
| heliyon | Matrix levels of metalloproteinase-2 (MMP-2) and toxicity evaluation of carbonate apatite-based endodontic sealer in rat subcutaneous implantation Pubmed: 32671254 |
| J Cell Physiol | A novel role of VEPH1 in regulating AoSMC phenotypic switching Pubmed: 32342520 |
| Advances in Animal and Veterinary Sciences | Clinicopathological studies and new markers for trypanosoma evansi in experimen-tally infected rats |
| Alteration on MMP-2 Levels in Women Diabetes Patients in Basrah | |
| Veterinary Sciences: Research and Reviews | Investigation of matrix metalloproteinase-2 and matrix metalloproteinase-9 activity in some inflammatory conditions in Barki sheep |
| MEDIATORS OF INFLAMMATION | MMP-9 Concentration in Peritoneal Fluid Is a Valuable Biomarker Associated with Endotoxemia in Equine Colic 33488296 |
| Oncol Lett | GATA3 is downregulated in HCC and accelerates HCC aggressiveness by transcriptionally inhibiting slug expression 33613720 |
| Journal of Pregnancy | Matrix Metalloproteinases MMP-2 and MMP-9 Occupy a New Role in Severe Preeclampsia 33381317 |
| Immunopharmacol Immunotoxicol | Tofacitinib enhances remyelination and improves myelin integrity in cuprizone-induced mice 34618622 |
| Exp Cell Res | Netrin-like domain of sFRP4, a Wnt antagonist inhibits stemness, metastatic and invasive properties by specifically blocking MMP-2 in cancer stem cells from human … 34762897 |
| Sci Rep | Curcumin derivative ST09 modulates the miR-199a-5p/DDR1 axis and regulates proliferation and migration in ovarian cancer cells 34837026 |
| Calcium Binding Protein S100A16 Expedites Proliferation, Invasion and EMT Process in Gastric Cancer 34650982 | |
| Medicina (Kaunas) | Plasma Concentrations of New Biochemical Markers of Atherosclerosis in Patients with Dyslipidemia—A Pilot Study Pubmed:35743980 |
| Journal of Pharmaceutical Research International | Concomitant Administration of Rosuvastatin and Lefleunamide in Low doses Synergize Against Complete Freund's Adjuvant (CFA)-Induced Rheumatoid … |
| Non-POU Domain-Containing Octamer-Binding (NONO) Protein Stability Regulated by PIN1 is Crucial for Breast Cancer Tumorigenicity Via the MAPK/β … | |
| Turkish Journal of Biochemistry-Turk Biyokimya Dergisi | Downregulation of MMP-2 and MMP-9 genes in obesity patients and their relation with obesity-related phenotypes |